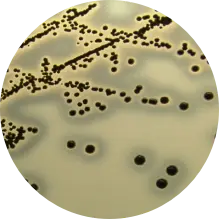
BP培养基上的金黄色葡萄球菌
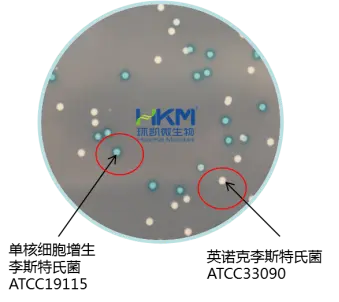
单核细胞增生李斯特氏菌

多起与微生物污染相关的食品安全事件震惊全网
发布时间:2025-07-10 浏览次数:458 分享:
近期,多起与微生物污染相关的食品安全事件引发广泛关注,揭示了餐饮行业在卫生管理、监管执行和标准落实等方面存在的深层次问题。以下是几起典型的微生物相关食品安全事件及其暴露的问题:

1. 云海肴新加坡食物中毒事件(金黄色葡萄球菌超标)
事件概述:2024年7月,字节跳动新加坡员工因食用云海肴供应的炒鸡丁后,130人出现食物中毒症状,部分员工甚至呕吐至瘫倒。检测发现,该菜品金黄色葡萄球菌含量超标2000倍(2×105 CFU/g,远超新加坡标准100 CFU/g)。此外,检查时还发现餐厅内有活蟑螂。
小贴士:金黄色葡萄球菌是革兰阳性球菌,为一种常见的食源性致病微生物,在适当的条件下,能产生肠毒素,引发食物中毒。有“嗜肉菌”的别称,该菌最适宜生长温度为37℃,pH为7.4,耐高盐,可在盐浓度接近10%的环境中生长。
BP培养基上的金黄色葡萄球菌:圆形、光滑凸起、湿润,直径约2~3mm,颜色呈灰色到黑色,边缘为淡色,周围为一混浊带,在其外层有一透明圈
暴露问题:
后厨卫生管理严重缺失:蟑螂滋生表明餐厅未严格执行害虫防控措施。
食品储存与加工不当:金黄色葡萄球菌通常因食物储存温度不当或员工手部卫生不良导致。
2. 广州网红面包店“黄油与面包”细菌感染事件
事件概述:2025年6月底,多名消费者在食用该店面包后出现腹泻、发烧等症状,部分确诊为细菌感染急性胃肠炎。官方通报排除了病毒感染,但微生物检测结果尚未公布。
暴露问题:
开放式陈列的卫生风险:面包仅用薄塑料膜覆盖,易受空气污染。
企业自检机制失效:尽管商家声称每月送检,但仍发生群体性不适事件,说明检测可能未覆盖关键风险点。
3. 广东烧鸭菌落总数超标事件
事件概述:2025年3月,广东抽检发现两家食品加工店生产的烧鸭菌落总数严重超标(最高达1.7×106 CFU/g),远超地方标准(可接受限值10⁵ CFU/g)。
暴露问题:
小作坊加工卫生条件差:可能因设备清洁不足或原料初始污染导致。
冷链或储存环节失控:菌落总数超标常与温度管理不当有关。
4. 塞尔维亚烟熏三文鱼检出李斯特菌
事件概述:2025年7月,意大利通报塞尔维亚出口的烟熏三文鱼被检出李斯特菌,产品被召回。
小贴士:单核细胞增生李斯特氏菌是一种革兰阳性短杆菌,无芽孢。极端环境中可生存,对盐、低pH、低温耐受,可应对环境胁迫时可形成生物膜。最“擅长”在冰箱这种低温环境中长期潜伏。
暴露问题:高风险食品加工管控不足:即食食品(如烟熏鱼类)易受李斯特菌污染,需严格杀菌和包装控制。
5. 意大利奶酪检出大肠杆菌和李斯特菌
事件概述:同月,卢森堡通报意大利出口奶酪因检出这两种致病菌被撤回。
暴露问题:乳制品生产卫生漏洞:可能源于原料污染或加工环境交叉感染。
揭示的核心问题
卫生标准执行不力:无论是大型连锁餐饮(如云海肴)还是小型加工厂,均存在清洁消毒流程疏漏,显示企业对基础卫生规范的忽视。
监管与自检机制失效:部分企业虽有送检制度,但未能预防问题发生,说明检测可能未覆盖关键环节或频率不足。
高风险食品管控不足:如即食食品、乳制品、肉制品等更易滋生致病菌,需更严格的工艺控制。
全球化供应链风险:进口食品的微生物污染事件增多,凸显国际食品安全协作的必要性。
行业改进方向
强化企业主体责任:建立从原料到成品的全程微生物监控体系,尤其关注高风险环节(如冷却、包装)。
引入先进消毒技术:如食品级复合型消毒剂应对顽固性生物膜和霉菌。
加强监管透明度:公开问题企业处罚信息,推动消费者监督。
这些事件表明,微生物污染仍是食品安全的主要威胁,需行业、监管和消费者共同发力,才能筑牢“舌尖上的防线”。
数据来源:
1. 字节新加坡员工食物中毒案最新进展:云海肴CEO认罪 _ 游民星空 GamerSky.com
2. 130 人中毒、蟑螂成堆!这个网红品牌又翻车了_云海_门店_吕志韬 (sohu.com)
3. 多名消费者称食用广州一网红店面包后不适 官方通报:排除病毒感染 微生物检测结果未出 (ycwb.com)
4. 广东检出7批次不合格食品,有烧鸭、腊鹌鹑、豆干等_中国食品_食品资讯_食品伙伴网 (foodmate.net)
5. 塞尔维亚出口烟熏三文鱼被检出李斯特菌 (foodmate.net)
6. 意大利出口奶酪中检出大肠杆菌和李斯特菌_食品安全动态_标法舆情动态_食品安全合规服务_食品伙伴网 (foodmate.net)
来源:食品药品实验室。











